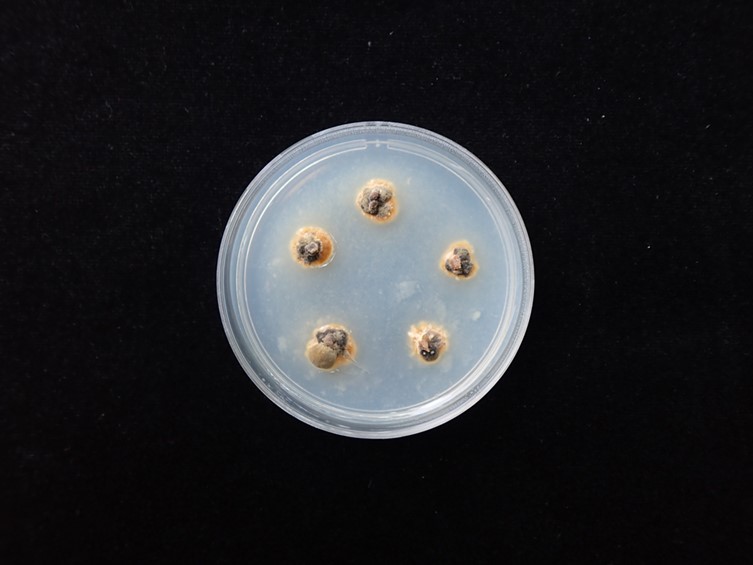

Habitat:
Bamboo culms.
Host:
Scale insect nymphs (Hemiptera).
Description:
 Stromata hemispherical, up to 12 mm diam, 8 mm high. Hywel-Jones and Samuels (1998) described the fresh specimen from Thailand as “strongly botryoso-tuberculate, cerebriform, very hard and resinous when fresh, irregularly furrowed, verrucose or irregularly tuberculate. Exterior color yellowish gray, yellowish brown to gray-brown or buff, becoming carbonaceous blackish brown to black. Interior pale cream-brown or yellow-brown or orange-yellow, becoming chalky white to cream-white.
Stromata hemispherical, up to 12 mm diam, 8 mm high. Hywel-Jones and Samuels (1998) described the fresh specimen from Thailand as “strongly botryoso-tuberculate, cerebriform, very hard and resinous when fresh, irregularly furrowed, verrucose or irregularly tuberculate. Exterior color yellowish gray, yellowish brown to gray-brown or buff, becoming carbonaceous blackish brown to black. Interior pale cream-brown or yellow-brown or orange-yellow, becoming chalky white to cream-white.  Perithecia scattered, embedded, pyriform, 260-560 × 145-260 μm in diam, body comparatively small, neck, long, ostioles slightly projecting, walls to 35 μm thick, Paraphyses not seen.
Perithecia scattered, embedded, pyriform, 260-560 × 145-260 μm in diam, body comparatively small, neck, long, ostioles slightly projecting, walls to 35 μm thick, Paraphyses not seen.  Asci 160-250 × 6-8 μm with caps 3 μm tall.
Asci 160-250 × 6-8 μm with caps 3 μm tall.  Part ascospores cylindrical with rounded ends, 8-11 × 1.5-2 μm.
Part ascospores cylindrical with rounded ends, 8-11 × 1.5-2 μm.
Culture characteristics:
Colonies on PDA are very slow-growing, attaining a diam of 5 mm after 8 wk, dark brown.
Colonies on PDA are very slow-growing, attaining a diam of 5 mm after 8 wk, dark brown.
Reference:
Chaverri P, Liu M, Hodge KT (2008). A monograph of the entomopathogenic genera Hypocrella, Moelleriella, and Samuelsia gen. nov. (Ascomycota, Hypocreales, Clavicipitaceae), and their aschersonia-like anamorphs in the Neotropics. Studies in Mycology 60: 1–66.
DOI: https://doi.org/10.3114/sim.2008.60.01Hywel-Jones NL, Samuels GJ (1998). Three species of Hypocrella with large stromata pathogenic on scale insects. Mycologia 90: 36–46.
Petch T (1921). Studies in entomogenous fungi: II. The genera Hypocrella and Aschersonia. Annals of the Royal Botanic Gardens Peradeniya 7: 167–278.
Species |
Strain |
Compound |
Pubchem CID |
Biological activity |
Reference |
|---|
|
Strain |
|---|